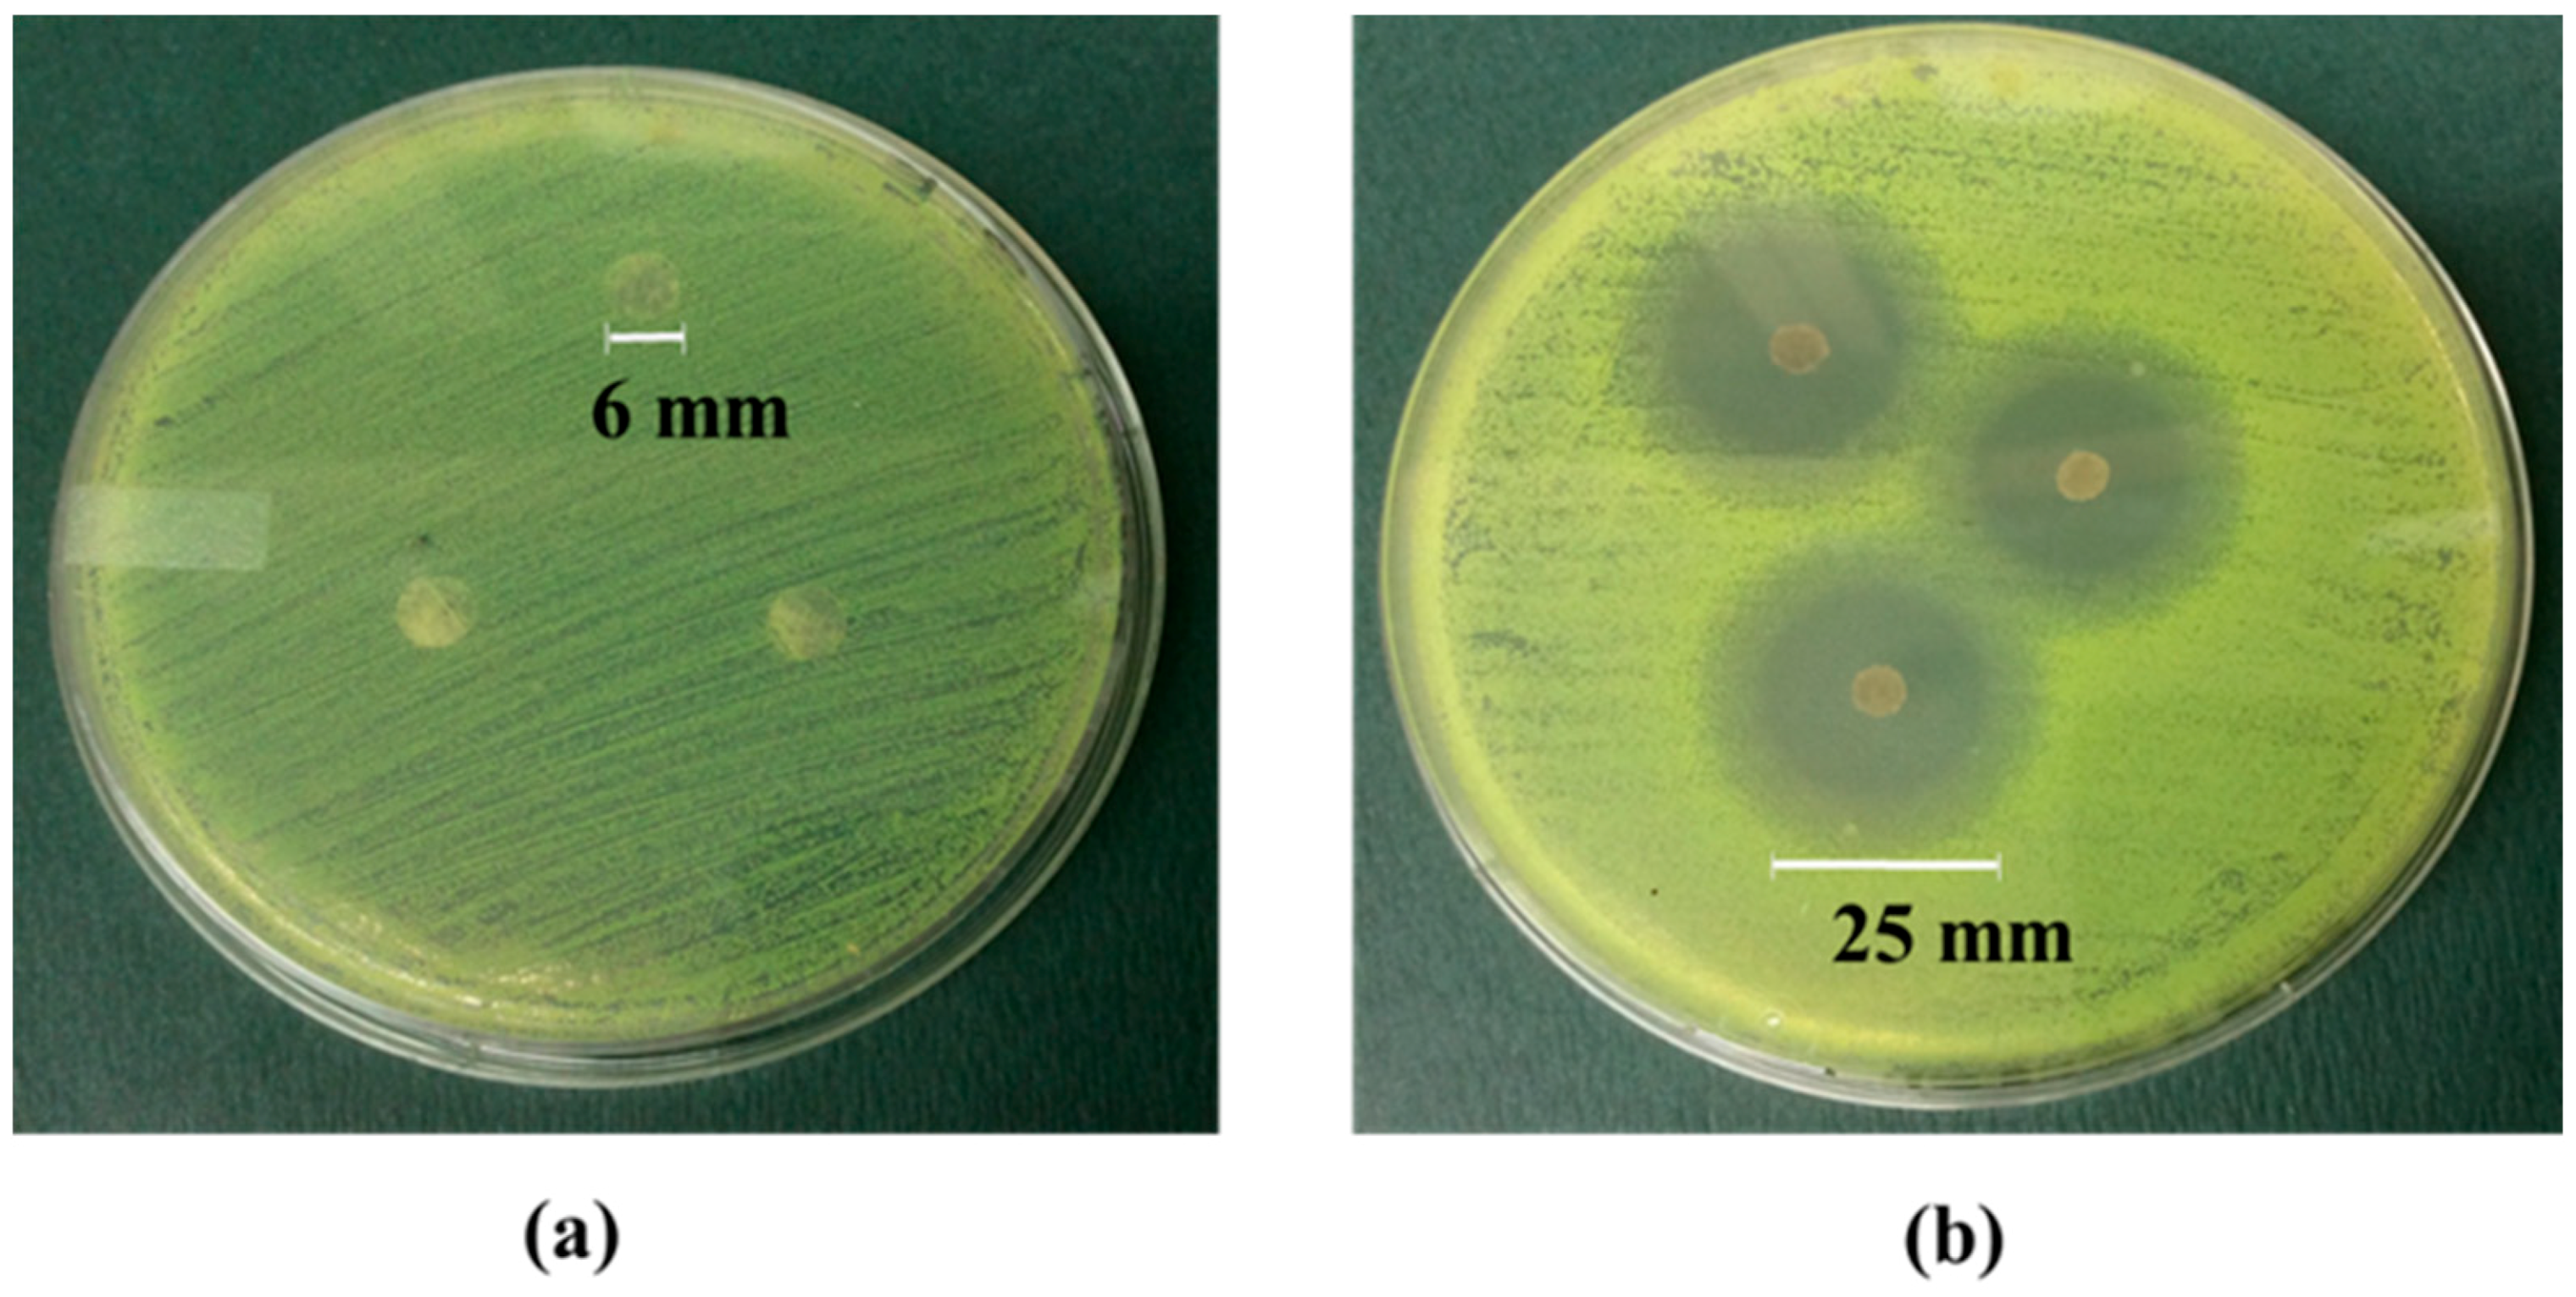
Fibers 07 00057 g006 Fibers 07 00057 g006

Cotton Cellulose-CdTe Quantum Dots Composite Films with Inhibition of Biofilm-Forming S. aureus
Abstract
1. Introduction
2. Experimental
2.1. Synthesis of Glutathione (GSH) Capped-CdTe QDs
2.2. Scouring and Bleaching Process of Waste Cotton
2.3. Preparation of Cellulose-GSH Capped CdTe QDs Composite Films
2.4. Material Characterization
2.4.1. Field Emission Scanning Electron Microscopy (FE-SEM) Imaging and Energy Dispersive X-ray (EDX) Analysis
2.4.2. Fourier Transform Infrared (FTIR) Spectroscopy
2.4.3. Thermogravimetric (TG) Analysis
2.4.4. X-ray Diffraction (XRD) Studies
2.4.5. Bacterial Strains, Media, and Growing Conditions
2.4.6. Agar Diffusion Assay
2.4.7. Quantitative Analysis of the Biofilms (CFU/Disk)
2.4.8. Analysis of the Biofilms by Confocal Laser Scanning Microscopy (CLSM)
2.4.9. Statistical Analysis
3. Results and Discussion
3.1. Morphology Study
3.2. FESEM Images and Elemental Analysis
3.3. FTIR Chemical Analysis
3.4. Thermal Analysis
3.5. XRD Analysis
3.6. Antibacterial Activity Tests
4. Conclusions
Author Contributions
Funding
Acknowledgments
Conflicts of Interest
References
- Kobayashi, S.D.; Malachowa, N.; DeLeo, F.R. Pathogenesis of Staphylococcus aureus Abscesses. Am. J. Pathol. 2015, 185, 1518–1527. [Google Scholar] [CrossRef] [PubMed]
- Tong, S.Y.C.; Davis, J.S.; Eichenberger, E.; Holland, T.L.; Fowler, V.G. Staphylococcus aureus Infections: Epidemiology, Pathophysiology, Clinical Manifestations, and Management. Clin. Microbiol. Rev. 2015, 28, 603–661. [Google Scholar] [CrossRef] [PubMed]
- Gould, D.; Chamberlaine, A. Staphylococcus ureus: A review of the literature. J. Clin. Nurs. 1995, 4, 5–12. [Google Scholar] [CrossRef] [PubMed]
- Thomer, L.; Schneewind, O.; Missiakas, D. Pathogenesis of Staphylococcus aureus Bloodstream Infections. Annu. Rev. Pathol. Mech. Dis. 2016, 11, 343–364. [Google Scholar] [CrossRef] [PubMed]
- Pantosti, A.; Sanchini, A.; Monaco, M. Mechanisms of antibiotic resistance in Staphylococcus aureus. Future Microbiol. 2007, 2, 323–334. [Google Scholar] [CrossRef] [PubMed]
- Chambers, H.F.; DeLeo, F.R. Waves of Resistance: Staphylococcus aureus in the Antibiotic Era. Nat. Rev. Microbiol. 2009, 7, 629–641. [Google Scholar] [CrossRef] [PubMed]
- Yoshii, Y.; Okuda, K.-I.; Yamada, S.; Nagakura, M.; Sugimoto, S.; Nagano, T.; Okabe, T.; Kojima, H.; Iwamoto, T.; Kuwano, K.; et al. Norgestimate inhibits staphylococcal biofilm formation and resensitizes methicillin-resistant Staphylococcus aureus to β-lactam antibiotics. NPJ Biofilms Microbiomes 2017, 3, 18. [Google Scholar] [CrossRef] [PubMed]
- Melchior, M.B.; Vaarkamp, H.; Fink-Gremmels, J. Biofilms: A role in recurrent mastitis infections? Vet. J. (Lond. Engl. 1997) 2006, 171, 398–407. [Google Scholar] [CrossRef]
- Song, M.; Li, Q.; Zhang, Y.; Song, J.; Shi, X.; Shi, C. Biofilm formation and antibiotic resistance pattern of dominant Staphylococcus aureus clonal lineages in China. J. Food Saf. 2017, 37, e12304. [Google Scholar] [CrossRef]
- Costerton, J.W.; Stewart, P.S.; Greenberg, E.P. Bacterial biofilms: A common cause of persistent infections. Sci. (N. Y.) 1999, 284, 1318–1322. [Google Scholar] [CrossRef]
- Khan, A.U.; Sultan, A.; Tyagi, A.; Zahoor, S.; Akram, M.; Kaur, S.; Shahid, M.; Vaishnavi, C.V. Amplification of mecA gene in multi-drug resistant Staphylococcus aureus strains from hospital personnel. J. Infect. Dev. Ctries. 2007, 1, 289–295. [Google Scholar] [CrossRef] [PubMed]
- Suhas Gupta, V.K.; Carrott, P.J.M.; Singh, R.; Chaudhary, M.; Kushwaha, S. Cellulose: A review as natural, modified and activated carbon adsorbent. Bioresour. Technol. 2016, 216, 1066–1076. [Google Scholar] [CrossRef] [PubMed]
- Ummartyotin, S.; Manuspiya, H. A critical review on cellulose: From fundamental to an approach on sensor technology. Renew. Sustain. Energy Rev. 2015, 41, 402–412. [Google Scholar] [CrossRef]
- Wang, X.; Yao, C.; Wang, F.; Li, Z. Cellulose-Based Nanomaterials for Energy Applications. Small (Weinh. Bergstr. Ger.) 2017, 13. [Google Scholar] [CrossRef] [PubMed]
- Czaja, W.K.; Young, D.J.; Kawecki, M.; Brown, R.M. The Future Prospects of Microbial Cellulose in Biomedical Applications. Biomacromolecules 2007, 8, 1–12. [Google Scholar] [CrossRef] [PubMed]
- Rezaei, A.; Nasirpour, A.; Fathi, M. Application of Cellulosic Nanofibers in Food Science Using Electrospinning and Its Potential Risk. Compr. Rev. Food Sci. Food Saf. 2015, 14, 269–284. [Google Scholar] [CrossRef]
- Li, S.; Huang, J.; Chen, Z.; Chen, G.; Lai, Y. A review on special wettability textiles: Theoretical models, fabrication technologies and multifunctional applications. J. Mater. Chem. A 2017, 5, 31–55. [Google Scholar] [CrossRef]
- Sulaeva, I.; Henniges, U.; Rosenau, T.; Potthast, A. Bacterial cellulose as a material for wound treatment: Properties and modifications. A review. Biotechnol. Adv. 2015, 33, 1547–1571. [Google Scholar] [CrossRef] [PubMed]
- Wang, J.; Vermerris, W. Antimicrobial Nanomaterials Derived from Natural Products—A Review. Materials 2016, 9, 255. [Google Scholar] [CrossRef] [PubMed]
- Naseri-Nosar, M.; Ziora, Z.M. Wound dressings from naturally-occurring polymers: A review on homopolysaccharide-based composites. Carbohydr. Polym. 2018, 189, 379–398. [Google Scholar] [CrossRef] [PubMed]
- Portela, R.; Leal, C.R.; Almeida, P.L.; Sobral, R.G. Bacterial cellulose: A versatile biopolymer for wound dressing applicaions. Microb. Biotechnol. 2019, 12, 586–610. [Google Scholar] [CrossRef] [PubMed]
- Fernandes, S.C.M.; Sadocco, P.; Alonso-Varona, A.; Palomares, T.; Eceiza, A.; Silvestre, A.J.D.; Mondragon, I.; Freire, C.S.R. Bioinspired Antimicrobial and Biocompatible Bacterial Cellulose Membranes Obtained by Surface Functionalization with Aminoalkyl Groups. ACS Appl. Mater. Interfaces 2013, 5, 3290–3297. [Google Scholar] [CrossRef]
- Saini, S.; Belgacem, M.N.; Salon, M.-C.B.; Bras, J. Non leaching biomimetic antimicrobial surfaces via surface functionalisation of cellulose nanofibers with aminosilane. Cellulose 2016, 23, 795–810. [Google Scholar] [CrossRef]
- Roemhild, K.; Wiegand, C.; Hipler, U.C.; Heinze, T. Novel bioactive amino-functionalized cellulose nanofibers. Macromol. Rapid Commun. 2013, 34, 1767–1771. [Google Scholar] [CrossRef] [PubMed]
- Jian, W.; Yudong, Z.; Xiaoxiao, W.; Qinghua, L.; Xiaohua, C.; Zhigu, W. Silver nanoparticle/bacterial cellulose gel membranes for antibacterial wound dressing: Investigation in vitro and in vivo. Biomed. Mater. 2014, 9, 035005. [Google Scholar]
- Barud, H.S.; Regiani, T.; Marques, R.F.C.; Lustri, W.R.; Messaddeq, Y.; Ribeiro, S.J.L. Antimicrobial Bacterial Cellulose-Silver Nanoparticles Composite Membranes. J. Nanomater. 2011, 2011, 8. [Google Scholar] [CrossRef]
- Jia, B.; Mei, Y.; Cheng, L.; Zhou, J.; Zhang, L. Preparation of copper nanoparticles coated cellulose films with antibacterial properties through one-step reduction. ACS Appl. Mater. Interfaces 2012, 4, 2897–2902. [Google Scholar] [CrossRef] [PubMed]
- Eivazihollagh, A.; Bäckström, J.; Dahlström, C.; Dahlström, C.; Carlsson, F.; Ibrahem, I.; Lindman, B.; Edlund, H.; Norgren, M. One-pot synthesis of cellulose-templated copper nanoparticles with antibacterial properties. Mater. Lett. 2017, 187, 170–172. [Google Scholar] [CrossRef]
- Luo, Y.; Huang, J. Hierarchical-Structured Anatase-Titania/Cellulose Composite Sheet with High Photocatalytic Performance and Antibacterial Activity. Chem. Eur. J. 2015, 21, 2568–2575. [Google Scholar] [CrossRef] [PubMed]
- Khalid, A.; Ullah, H.; Ul-Islam, M.; Khan, R.; Khan, S.; Ahmad, F.; Khan, T.; Wahid, F. Bacterial cellulose-TiO2 nanocomposites promote healing and tissue regeneration in burn mice model. RSC Adv. 2017, 7, 47662–47668. [Google Scholar] [CrossRef]
- Fu, F.; Li, L.; Liu, L.; Cai, J.; Zhang, Y.; Zhou, J.; Zhang, L. Construction of Cellulose Based ZnO Nanocomposite Films with Antibacterial Properties through One-Step Coagulation. ACS Appl. Mater. Interfaces 2015, 7, 2597–2606. [Google Scholar] [CrossRef] [PubMed]
- Azizi, S.; Ahmad, M.B.; Hussein, M.Z.; Ibrahim, N.A. Synthesis, antibacterial and thermal studies of cellulose nanocrystal stabilized ZnO-Ag heterostructure nanoparticles. Molecules 2013, 18, 6269–6280. [Google Scholar] [CrossRef] [PubMed]
- Courtney, C.M.; Goodman, S.M.; McDaniel, J.A.; Madinger, N.E.; Chatterjee, A.; Nagpal, P. Photoexcited quantum dots for killing multidrug-resistant bacteria. Nat. Mater. 2016, 15, 529. [Google Scholar] [CrossRef] [PubMed]
- Galdiero, E.; Siciliano, A.; Maselli, V.; Gesuele, R.; Guida, M.; Fulgione, D.; Galdiero, S.; Lombardi, L.; Falanga, A. An integrated study on antimicrobial activity and ecotoxicity of quantum dots and quantum dots coated with the antimicrobial peptide indolicidin. Int. J. Nanomed. 2016, 11, 4199–4211. [Google Scholar] [CrossRef] [PubMed]
- He, X.; Ma, N. An overview of recent advances in quantum dots for biomedical applications. Colloids Surf. B Biointerfaces 2014, 124, 118–131. [Google Scholar] [CrossRef] [PubMed]
- Yang, Z.; Fan, J.Z.; Proppe, A.H.; de Arquer, F.P.G.; Rossouw, D.; Voznyy, O.; Lan, X.; Liu, M.; Walters, G.; Quintero-Bermudez, R.; et al. Mixed-quantum-dot solar cells. Nat. Commun. 2017, 8, 1325. [Google Scholar] [CrossRef] [PubMed]
- Kamat, P.V. Quantum Dot Solar Cells. The Next Big Thing in Photovoltaics. J. Phys. Chem. Lett. 2013, 4, 908–918. [Google Scholar] [CrossRef] [PubMed]
- Paivasaari, K.; Tikhomirov, V.K.; Turunen, J. High refractive index chalcogenide glass for photonic crystal applications. Opt. Express 2007, 15, 2336–2340. [Google Scholar] [CrossRef] [PubMed]
- Rizvi, S.B.; Ghaderi, S.; Keshtgar, M.; Seifalian, A.M. Semiconductor quantum dots as fluorescent probes for in vitro and in vivo bio-molecular and cellular imaging. Nano Rev. 2010, 1. [Google Scholar] [CrossRef]
- Cabral Filho, P.E.; Cardoso, A.L.C.; Pereira, M.I.A.; Ramos, A.P.M.; Hallwass, F.; Castro, M.M.C.A.; Geraldes, C.F.G.C.; Santos, B.S.; Pedroso de Lima, M.C.; Pereira, G.A.L.; et al. CdTe quantum dots as fluorescent probes to study transferrin receptors in glioblastoma cells. Biochim. Et Biophys. Acta (BBA) Gen. Subj. 2016, 1860, 28–35. [Google Scholar] [CrossRef]
- Tan, X.; Liu, S.; Shen, Y.; He, Y.; Liu, Y.; Yang, J. Glutathione-capped CdTe quantum dots for the determination of fleroxacin with dual-wavelength fluorescence signals. Anal. Methods 2014, 6, 4860–4866. [Google Scholar] [CrossRef]
- Jacob, J.M.; Lens, P.N.L.; Balakrishnan, R.M. Microbial synthesis of chalcogenide semiconductor nanoparticles: A review. Microb. Biotechnol. 2016, 9, 11–21. [Google Scholar] [CrossRef]
- Yu, W.W.; Chang, E.; Drezek, R.; Colvin, V.L. Water-soluble quantum dots for biomedical applications. Biochem. Biophys. Res. Commun. 2006, 348, 781–786. [Google Scholar] [CrossRef] [PubMed]
- Wansapura Poorna, T.; Dassanayake Rohan, S.; Hamood, A.; Tran, P.; Moussa, H.; Abidi, N. Preparation of chitin-CdTe quantum dots films and antibacterial effect on Staphylococcus aureus and Pseudomonas aeruginosa. J. Appl. Polym. Sci. 2017, 134. [Google Scholar] [CrossRef]
- Pérez-Donoso, J.M.; Monrás, J.P.; Bravo, D.; Aguirre, A.; Quest, A.F.; Osorio-Román, I.O.; Aroca, R.F.; Chasteen, T.G.; Vásquez, C.C. Biomimetic, Mild Chemical Synthesis of CdTe-GSH Quantum Dots with Improved Biocompatibility. PLoS ONE 2012, 7, e30741. [Google Scholar] [CrossRef] [PubMed]
- Wansapura, P.T.; Diaz-Vasquez, W.A.; Vasquez, C.C.; Perez-Donoso, J.M.; Chasteen, T.G. Thermal and photo stability of glutathione-capped cadmium telluride quantum dots. J. Appl. Biomater. Funct. Mater. 2015, 13, e248–e252. [Google Scholar] [CrossRef]
- Tran, P.L.; Lowry, N.; Campbell, T.; Reid, T.W.; Webster, D.R.; Tobin, E.; Aslani, A.; Mosley, T.; Dertien, J.; Colmer-Hamood, J.A.; et al. An Organoselenium Compound Inhibits Staphylococcus aureus Biofilms on Hemodialysis Catheters In Vivo. Antimicrob. Agents Chemother. 2012, 56, 972–978. [Google Scholar] [CrossRef] [PubMed]
- Haydous, F.; Halaoui, L. Quantum-Confined CdTe Films Deposited by SILAR and Their Photoelectrochemical Stability in the Presence of Se2– as a Hole Scavenger. J. Phys. Chem. C 2014, 118, 18334–18342. [Google Scholar] [CrossRef]
- Monrás, J.P.; Díaz, V.; Bravo, D.; Montes, R.A.; Chasteen, T.G.; Osorio-Román, I.O.; Vásquez, C.C.; Pérez-Donoso, J.M. Enhanced Glutathione Content Allows the In Vivo Synthesis of Fluorescent CdTe Nanoparticles by Escherichia coli. PLoS ONE 2012, 7, e48657. [Google Scholar] [CrossRef]
- Abidi, N.; Cabrales, L.; Haigler, C.H. Changes in the cell wall and cellulose content of developing cotton fibers investigated by FTIR spectroscopy. Carbohydr. Polym. 2014, 100, 9–16. [Google Scholar] [CrossRef]
- Dassanayake, R.S.; Gunathilake, C.; Jackson, T.; Jaroniec, M.; Abidi, N. Preparation and adsorption properties of aerocellulose-derived activated carbon monoliths. Cellulose 2016, 23, 1363–1374. [Google Scholar] [CrossRef]
- Abidi, N.; Hequet, E.; Cabrales, L.; Gannaway, J.; Wilkins, T.; Wells, L.W. Evaluating cell wall structure and composition of developing cotton fibers using Fourier transform infrared spectroscopy and thermogravimetric analysis. J. Appl. Polym. Sci. 2008, 107, 476–486. [Google Scholar] [CrossRef]
- Lu, Z.; Li, C.M.; Bao, H.; Qiao, Y.; Toh, Y.; Yang, X. Mechanism of Antimicrobial Activity of CdTe Quantum Dots. Langmuir 2008, 24, 5445–5452. [Google Scholar] [CrossRef] [PubMed]
- Dumas, E.; Gao, C.; Suffern, D.; Bradforth, S.E.; Dimitrijevic, N.M.; Nadeau, J.L. Interfacial Charge Transfer between CdTe Quantum Dots and Gram Negative Vs. Gram Positive Bacteria. Environ. Sci. Technol. 2010, 44, 1464–1470. [Google Scholar] [CrossRef] [PubMed]
- Rameshkumar, A.; Sivasudha, T.; Jeyadevi, R.; Sangeetha, B.; Ananth, D.A.; Aseervatham, G.S.; Nagarajan, N.; Renganathan, R.; Kathiravan, A. In vitro antioxidant and antimicrobial activities of Merremia emarginata using thio glycolic acid-capped cadmium telluride quantum dots. Colloids Surf. Bbiointerfaces 2013, 101, 74–82. [Google Scholar] [CrossRef]
- Kumar, H.; Srivastava, R.; Dutta, P.K. Highly luminescent chitosan-L-cysteine functionalized CdTe quantum dots film: Synthesis and characterization. Carbohydr. Polym. 2013, 97, 327–334. [Google Scholar] [CrossRef]
- Abdelhamid, H.N.; Wu, H.-F. Probing the interactions of chitosan capped CdS quantum dots with pathogenic bacteria and their biosensing application. J. Mater. Chem. B 2013, 1, 6094–6106. [Google Scholar] [CrossRef]
- Neelgund, G.M.; Oki, A.; Luo, Z. Antimicrobial activity of CdS and Ag(2)S quantum dots immobilized on poly(amidoamine) grafted carbon nanotubes. Colloids Surf. Bbiointerfaces 2012, 100, 215–221. [Google Scholar] [CrossRef]
- Luo, Z.; Wu, Q.; Zhang, M.; Li, P.; Ding, Y. Cooperative antimicrobial activity of CdTe quantum dots with rocephin and fluorescence monitoring for Escherichia coli. J. Colloid Interface Sci. 2011, 362, 100–106. [Google Scholar] [CrossRef]
- Soonhyang, P.; Hicham, C.; Jody, W.; Jay, L.N. Antimicrobial activity and cellular toxicity of nanoparticle–polymyxin B conjugates. Nanotechnology 2011, 22, 185101. [Google Scholar]
- Han, Y.; Zhang, X.; Wu, X.; Lu, C. Flame Retardant, Heat Insulating Cellulose Aerogels from Waste Cotton Fabrics by in Situ Formation of Magnesium Hydroxide Nanoparticles in Cellulose Gel Nanostructures. ACS Sustain. Chem. Eng. 2015, 3, 1853–1859. [Google Scholar] [CrossRef]
- He, X.; Zhang, X.; Zhang, W.; Tian, D.; Lu, C. Mechanochemically activated waste-derived cellulose as a novel functional additive to enhance melt processability and mechanical properties of poly (vinyl alcohol). J. Vinyl Addit. Technol. 2014, 20, 177–184. [Google Scholar] [CrossRef]
- Xiong, R.; Zhang, X.; Tian, D.; Zhou, Z.; Lu, C. Comparing microcrystalline with spherical nanocrystalline cellulose from waste cotton fabrics. Cellulose 2012, 19, 1189–1198. [Google Scholar] [CrossRef]
- Huang, F.; Xu, Y.; Peng, B.; Su, Y.; Jiang, F.; Hsieh, Y.-L.; Wei, Q. Coaxial Electrospun Cellulose-Core Fluoropolymer-Shell Fibrous Membrane from Recycled Cigarette Filter as Separator for High Performance Lithium-Ion Battery. ACS Sustain. Chem. Eng. 2015, 3, 932–940. [Google Scholar] [CrossRef]
- Lam, E.; Leung, A.C.W.; Liu, Y.; Majid, E.; Hrapovic, S.; Male, K.B.; Luong, J.H.T. Green Strategy Guided by Raman Spectroscopy for the Synthesis of Ammonium Carboxylated Nanocrystalline Cellulose and the Recovery of Byproducts. ACS Sustain. Chem. Eng. 2013, 1, 278–283. [Google Scholar] [CrossRef]
- Salam, A.; Lucia, L.A.; Jameel, H. A Novel Cellulose Nanocrystals-Based Approach to Improve the Mechanical Properties of Recycled Paper. ACS Sustain. Chem. Eng. 2013, 1, 1584–1592. [Google Scholar] [CrossRef]
- Xiao, L.; Mai, Y.; He, F.; Yu, L.; Zhang, L.; Tang, H.; Yang, G. Bio-based green composites with high performance from poly (lactic acid) and surface-modified microcrystalline cellulose. J. Mater. Chem. 2012, 22, 15732–15739. [Google Scholar] [CrossRef]

© 2019 by the authors. Licensee MDPI, Basel, Switzerland. This article is an open access article distributed under the terms and conditions of the Creative Commons Attribution (CC BY) license (http://creativecommons.org/licenses/by/4.0/).
Share and Cite
Dassanayake, R.S.; Wansapura, P.T.; Tran, P.; Hamood, A.; Abidi, N. Cotton Cellulose-CdTe Quantum Dots Composite Films with Inhibition of Biofilm-Forming S. aureus. Fibers 2019, 7, 57. https://doi.org/10.3390/fib7060057
Dassanayake RS, Wansapura PT, Tran P, Hamood A, Abidi N. Cotton Cellulose-CdTe Quantum Dots Composite Films with Inhibition of Biofilm-Forming S. aureus. Fibers. 2019; 7(6):57. https://doi.org/10.3390/fib7060057
Chicago/Turabian StyleDassanayake, Rohan S., Poorna T. Wansapura, Phat Tran, Abdul Hamood, and Noureddine Abidi. 2019. "Cotton Cellulose-CdTe Quantum Dots Composite Films with Inhibition of Biofilm-Forming S. aureus" Fibers 7, no. 6: 57. https://doi.org/10.3390/fib7060057
APA StyleDassanayake, R. S., Wansapura, P. T., Tran, P., Hamood, A., & Abidi, N. (2019). Cotton Cellulose-CdTe Quantum Dots Composite Films with Inhibition of Biofilm-Forming S. aureus. Fibers, 7(6), 57. https://doi.org/10.3390/fib7060057

